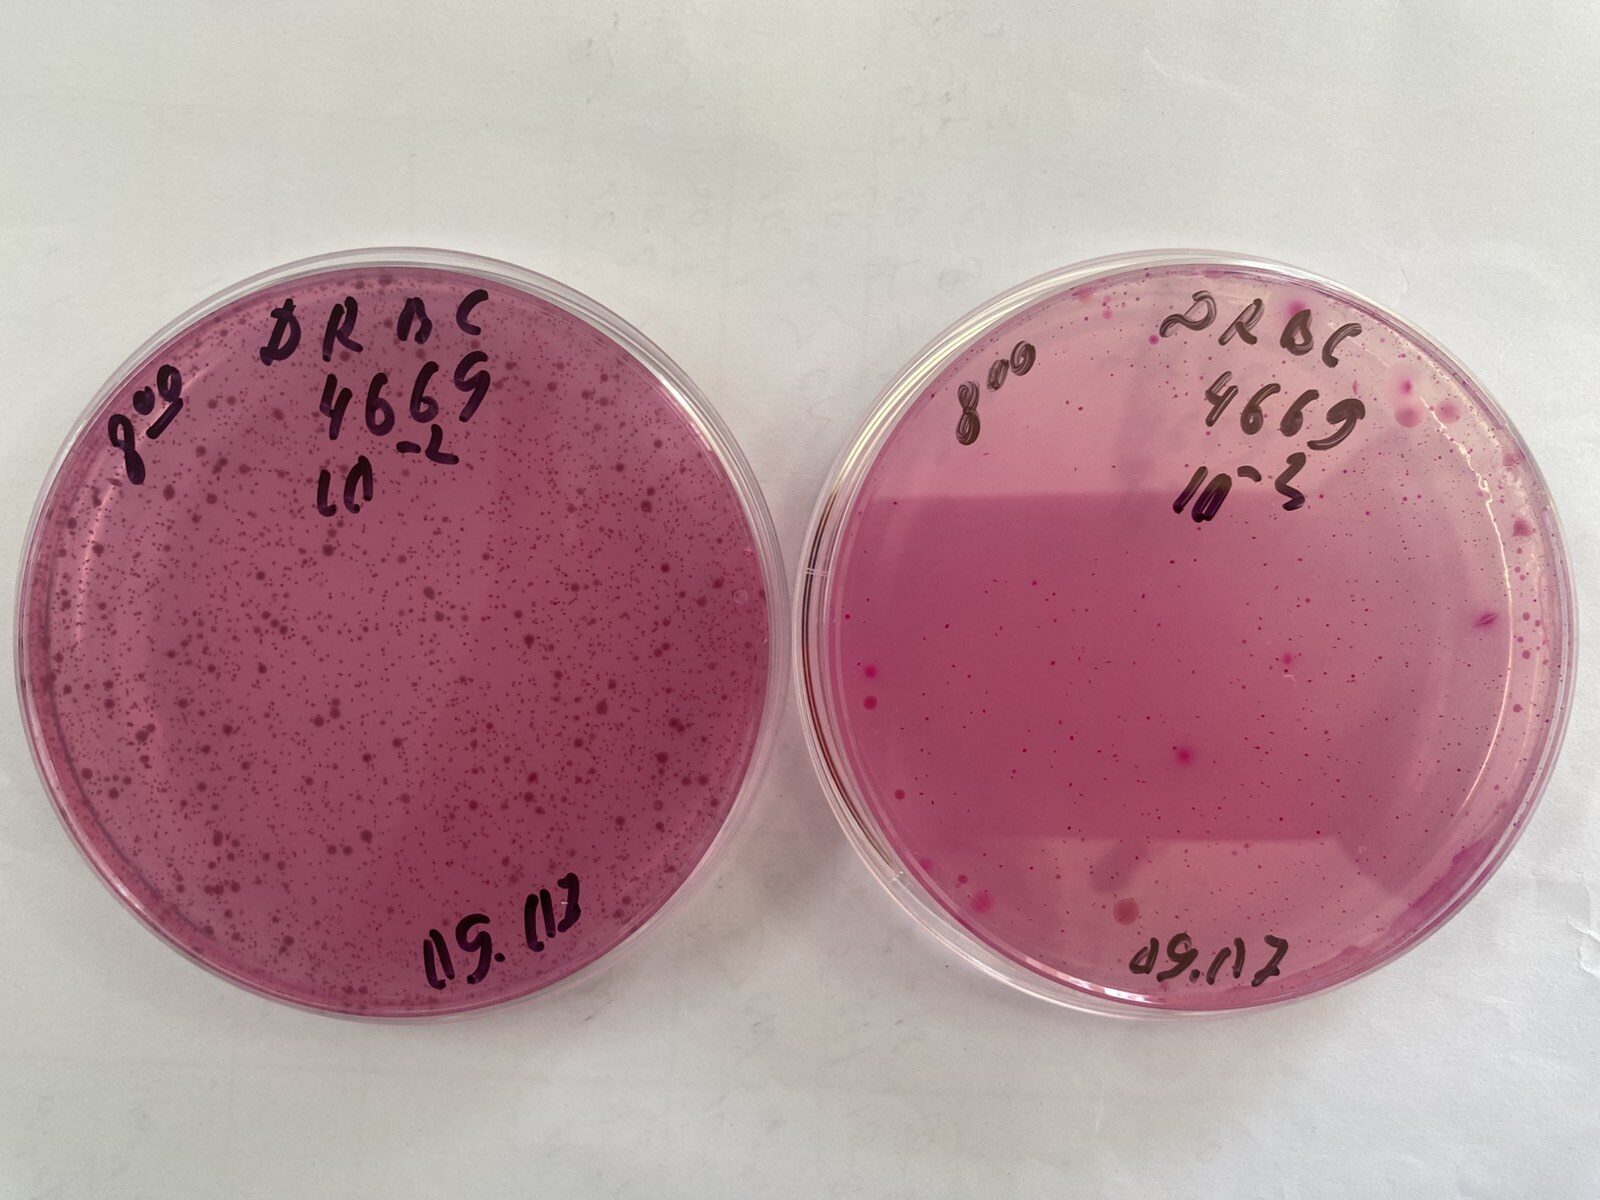

Agenția Națională pentru Siguranța Alimentelor (ANSA) a prezentat rezultatele unui experiment realizat în colaborare cu Laboratorul de încercări a produselor alimentare din cadrul Centrului Național Sănătatea Animalelor, Plantelor și Siguranța Alimentelor, prin care s-a demonstrat cât de rapid pot deveni periculoase alimentele perisabile atunci când sunt expuse la temperaturi ridicate.
Produsele testate – salam fiert, cașcaval, iaurt, ouă fierte și salată cu maioneză – au fost păstrate în condiții improprii, la temperaturi de 23–35°C, timp de 48 de ore, iar rezultatele au arătat modificări microbiologice alarmante încă din primele ore, scrie moldpres.
„În salata cu maioneză după 4 ore, s-au dezvoltat bacterii coliforme, iar în ziua a doua a fost detectată bacteria E. coli. Numărul coloniilor bacteriene a crescut de zeci de mii de ori, iar drojdiile și mucegaiurile s-au dezvoltat exponențial. În cazul ouălor fierte bacteriile coliforme au apărut în a doua zi, iar mirosul produsului a devenit impropriu pentru consum încă din prima zi. În iaurt drojdiile au fost detectate din prima zi, iar mucegaiurile în cea de-a doua zi. La mezelul fiert în a doua zi s-a constatat o creștere semnificativă a mucegaiului și a drojdiilor (de peste 300 de ori). În cazul caşcavalului, deși aspectul și mirosul nu s-au modificat vizibil, în primele 48 de ore, testele microbiologice au arătat apariția drojdiilor și mucegaiurilor, ceea ce poate induce în eroare consumatorii”, punctează ANSA.
ANSA avertizează că prezența bacteriilor coliforme și, în special, a E. coli, indică un risc major de toxiinfecții alimentare care pot cauza afecțiuni grave. De asemenea, mucegaiurile pot produce micotoxine periculoase pentru sănătate.
În acest sens, specialiștii recomandă să nu fie lăsate produsele perisabile la temperaturi ridicate mai mult de 2–4 ore.
„Transportați alimentele în recipiente termoizolante și păstrați-le la temperaturi optime. Evitați consumul produselor care prezintă modificări de aspect, miros sau gust”, recomandă Agenția Națională pentru Siguranța Alimentelor.